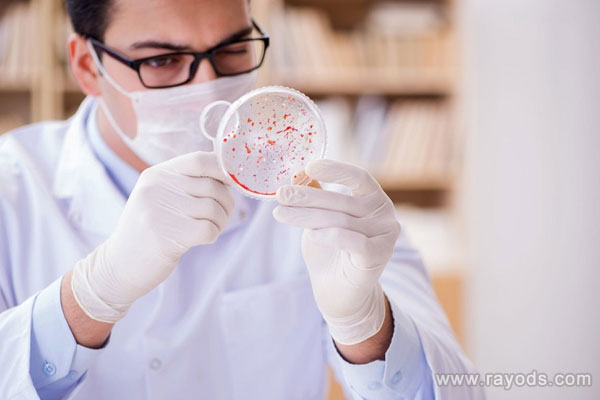
泰国杰特宁医院是公立还是私立的？

-

距离医院仅15分钟!杰特宁附近有这些酒店可选择
不少朋友去泰国杰特宁医院做试管婴儿,住哪个酒店是首先要解决的问题,尤其是初次到泰国的朋友更是要事先确定好,今天这里本文就为大家介绍下杰特宁医院附近的一些酒店,距..
2023-07-02 07:35 -

2022泰国三代试管医院排名出炉,最好的依然是杰特宁?
目前泰国三代试管婴儿医院排名靠前的医院有杰特宁医院、ART医院、BNH医院。这三家医院的三代试管婴儿技术在泰国是比较出名的,而且技术不会相差太大。所以想做三代试管婴儿..
2023-09-26 15:31 -

泰国杰特宁医院做试管婴儿选男孩需要多少钱?
泰国杰特宁医院做试管婴儿选男孩需要多少钱?我和丈夫有一个女儿,但是丈夫还是想要一个男孩,不是因为重男轻女,而仅仅是因为他想再要一个男孩,但是宝宝的准备工作一直拖..
2023-12-31 06:16 -

泰国杰特宁医院做试管婴儿要多少钱?附费明细参考
泰国杰特宁皇家医院创建于1996年,该院也是泰国首家成功采用GIFT方法治疗了不孕不育症的泰国试管婴儿医院, 也是泰国乃至亚洲首家成功采用TESE / ICSI方法,帮助男方不育的..
2024-01-02 06:11 -
男性艾滋病患者做泰国第三代试管婴儿杰特宁和bnh医院选择哪个更好
男性艾滋病患者做泰国第三代试管婴儿杰特宁和bnh医院选择哪个更好?随着不孕不育人群的增加,试管婴儿技术也不断的走进我们的生活中,生活中,当我们没有需求的时候,可能对..
2024-03-02 09:08 -
男性艾滋病患者做泰国第三代试管婴儿杰特宁医院价格贵吗,费用是多少
男性艾滋病患者做泰国第三代试管婴儿杰特宁医院价格贵吗,费用是多少?随着试管技术不断发展,这项技术也终于被更多的家庭认可了,泰国做第三代试管婴儿发展较快,成了海外..
2024-03-07 10:04 -

泰国杰特宁医院Jetanin在哪里?环境好么?
泰国杰特宁医院位于泰国曼谷,这家医院的环境很不错,能让患者在这儿有一个好的心情,这家医院的试管婴儿成功率也比较高。从机场去杰特宁医院:1.素万那普机场-杰特宁全程2..
2024-03-09 09:25 -

为什么都说泰国杰特宁医院Jetanin适合国内人前往呢?
泰国杰特宁医院在试管医院中算是非常出名的,医疗设施及试管技术都处于领先水平,此外该院的超高抱胎率以及极好的口碑都是很多国内人选择他的原因。泰国杰特宁医院具有以下..
2024-03-12 09:11 -

泰国杰特宁医院有HIV洗精的医生吗?
泰国杰特宁医院是可以做HIV洗精的,做完洗精之后再结合第三代试管婴儿技术就可以帮助艾滋病患者孕育自己的宝宝,且不会传播给下一代。hiv洗精方法:1、玻璃纤维滤过法,就..
2024-03-13 09:29 -

泰国杰特宁医院地址在哪里?是在曼谷市吗?
泰国杰特宁(Jetanin)研究所位于曼谷市巴吞汪区仑披尼分区普勒吉路齐隆巷5号,在泰国曼谷的巴吞旺县境内。如果要去往杰特宁研究所进行试管治疗可以选择中介服务,或者是选..
2024-03-14 09:01 -

泰国杰特宁医院医生介绍,哪个医生排名高
如果说泰国哪个试管婴儿医院在国内最出名,那必定是泰国杰特宁医院。因为杰特宁医院最早对中国客户开放,并且在中国宣传最久。泰国杰特宁医院成立于1996年,由Jongjate Aoj..
2024-03-14 09:22 -

泰国杰特宁医院做试管婴儿的价格是多少?12万够不够
泰国做试管婴儿每个医院的价格都相差不多,基本9-11万就够一个周期的了,杰特宁医院也是如此。但因为试管并不是百分之百成功,而且前往泰国还需要一系列的生活费用,建议准..
2024-03-14 09:28 -
泰国杰特宁医院是公立还是私立的?
泰国杰特宁医院属于私立医院,泰国的试管医院分为三种,公立医院、私立医院、私人诊所。一般现在从国内往泰国试管的医院都是私立医院。泰国三种试管医院的介绍:1、公立医..
2024-03-14 09:34 -

泰国杰特宁试管婴儿医院为什么它这么受欢迎?
泰国杰特宁成立于1996年,是泰国首家成功采用GIFT方法治疗了不孕不育症的医院,也是泰国乃至亚洲首家成功采用TESE / ICSI方法,帮助男方不育的夫妇拥有了自己的孩子的医院..
2024-03-15 09:01 -

做三代试管泰国杰特宁和BNH医院哪个好
杰特宁和BNH医院都是做三代试管婴儿比较出名的医院,在国际上都有很好的口碑,各有各的医疗特色,所以哪家医院好,也是分不出来的,要根据医院擅长的领域结合自身情况选择..
2024-03-15 09:05 -

高龄做试管去杰特宁医院和泰国全球生殖中心哪个好
高龄做试管去泰国全球生殖中心比较好,因为泰国全球生殖中心的主任医师提迪贡博士在高龄卵巢退化妇女的促排卵、胚胎养囊和移植方面有独到的技术和经验,是全泰国唯一跨国解..
2024-03-15 09:09 -

泰国杰特宁医院YOKO医生怎么样?移植成功率高不高?
泰国杰特宁医院总体的的试管成功率在70%左右,算是比较高的了,YOKO医生的试管技术高超,尤其擅长高龄妇女的试管,总体而言患者对她的反馈都是十分不错的。YOKO医生介绍:Y..
2024-03-15 09:14 -

32岁做试管去泰国杰特宁医院和ART哪个好?
对很多人去泰国做试管婴儿来说,选择医院是非常困难的,因为每个医院都有成功和失败的案例,但是并不是所有案例都被人知晓,所以没听到一个案例,都会对选择医院造成一定的..
2024-03-15 09:19 -

泰国杰特医院和帕亚泰哪个好?该选择哪家呢
这两家泰国试管医院各有优点,泰国杰特宁医院比较适合卵巢衰退、大龄情况、卵子数量较少的女性,而帕亚泰适合多囊、身体有一些其他问题的女性,因为是综合医院,治疗其他方..
2024-03-15 09:22 -

泰国杰特宁医院三代养囊成功率高吗?
泰国杰特宁医院做第三代试管婴儿的成功率大概在70%以上,第三代试管婴儿也可以排除很多关于遗传性的疾病,保证宝宝的健康。不过对囊胚的质量以及数量影响最大的还是患者自..
2024-03-15 09:27
微信分享
扫描二维码分享到微信或朋友圈